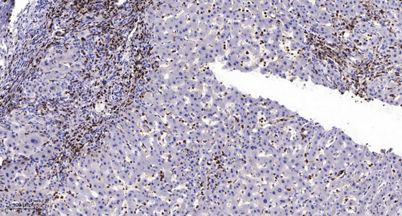

$148.00/50µL $248.00/100µL
| 50 µL | $148.00 |
| 100 µL | $248.00 |
| Product name: | MRP-S30 rabbit pAb |
| Reactivity: | Human;Rat;Mouse; |
| Alternative Names: | MRPS30; PDCD9; BM-047; 28S ribosomal protein S30; mitochondrial; MRP-S30; S30mt; Programmed cell death protein 9 |
| Source: | Rabbit |
| Dilutions: | WB 1:500-2000;IHC-p 1:50-300 |
| Immunogen: | The antiserum was produced against synthesized peptide derived from human MRPS30. AA range:390-439 |
| Storage: | -20°C/1 year |
| Clonality: | Polyclonal |
| Isotype: | IgG |
| Concentration: | 1 mg/ml |
| Observed Band: | 55kD |
| GeneID: | 10884 |
| Human Swiss-Prot No: | Q9NP92 |
| Cellular localization: | Mitochondrion . |
| Background: | Mammalian mitochondrial ribosomal proteins are encoded by nuclear genes and help in protein synthesis within the mitochondrion. Mitochondrial ribosomes (mitoribosomes) consist of a small 28S subunit and a large 39S subunit. They have an estimated 75% protein to rRNA composition compared to prokaryotic ribosomes, where this ratio is reversed. Another difference between mammalian mitoribosomes and prokaryotic ribosomes is that the latter contain a 5S rRNA. Among different species, the proteins comprising the mitoribosome differ greatly in sequence, and sometimes in biochemical properties, which prevents easy recognition by sequence homology. This gene encodes a 28S subunit protein that is similar to the chicken pro-apoptotic protein p52. Transcript variants using alternative promoters or polyA sites have been mentioned in the literature but the complete description of these sequences i |